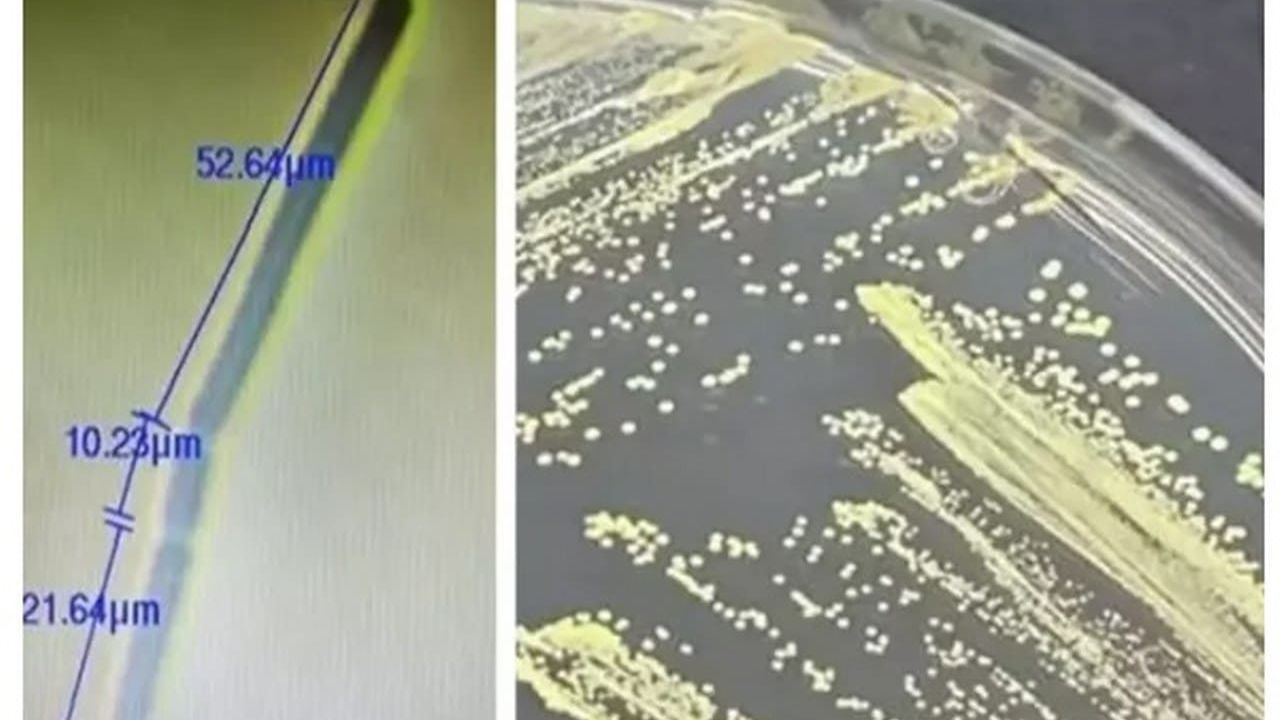

Einstein’ın keşifleri
- Mar- 2025 -26 MartBilim, teknoloji

Einstein’ın gerçekleşen 10 önemli teorisi
Albert Einstein’ın teorileri, zaman içinde yapılan gözlemler ve deneylerle doğrulandı. Kuarklar, kara delikler, yerçekimi dalgaları gibi önemli keşifler, bilim dünyasında…
Devamını Oku » - 13 MartGENEL KÜLTÜR

İslam dünyasının bilim dehaları: 23 Müslüman bilim adamı ve keşifleri
Tarihteki en büyük keşiflere imza atan Müslüman bilim insanları, Avrupa'dan yüzyıllar önce önemli buluşlar yaparak bilime katkı sağladılar. İşte o…
Devamını Oku » - Şub- 2025 -25 Şubat
Prof. Dr. Levent Gültekin, Keşfettiği Yeni Böcek Türüne Eşinin Adını Verdi
Atatürk Üniversitesi Ziraat Fakültesi Öğretim Üyesi Prof. Dr. Levent Gültekin, 25 yıllık bilimsel kariyerinin zirvesinde, Kop Dağı'nda keşfettiği yeni böcek…
Devamını Oku » - 16 ŞubatBİLİM VE TEKNOLOJİ

Türk Bilim İnsanlarından Çığır Açan Keşif!
İstanbul Üniversitesi’nden bilim insanları, uçak yakıtında yaşayabilen ve çevre kirliliğini önleme potansiyeli taşıyan yeni bir bakteri cinsi keşfetti.
Devamını Oku » - 7 ŞubatKÜLTÜR-SANAT

Şok edici keşif! Antik Mısır Tarihi yeniden yazılabilir
Dünya dışı bağlantılar hakkında spekülasyonlar artıyor
Devamını Oku » - Oca- 2025 -29 OcakYAŞAM

Avuç içlerinizi kontrol edin: Aşk hayatınızı keşfedin
Avuç içi çizgileriniz aşk hayatınız ve kişiliğinizi keşfetmenize yardımcı olacak. Sol çizgi yüksek, düşük veya eşit olan kişiler, farklı ilişki…
Devamını Oku » - Ara- 2024 -3 AralıkDünya

Çin’de Tarihi Altın Keşfi: Fiyatlar Tavan Yaptı!
Çin'de devasa bir altın rezervi keşfedildi! Dünyanın en büyük altın yatağı olarak kabul edilen bu keşif, altın fiyatlarını rekor seviyelere…
Devamını Oku » - Kas- 2024 -13 KasımBİLİM VE TEKNOLOJİ

Yaşını geri alabilen deniz canlısı keşfedildi: Bilim insanları yanlışlıkla büyük bir keşif yaptı
Bilim insanları, stres altında yaşını geri alabilen bir taraklı denizanası keşfetti. Olağanüstü bu özellik, yaşlanma süreci hakkında yeni bir anlayışa…
Devamını Oku » - Haz- 2024 -15 HaziranErzincan - Genel

Hakkari’den Uludağ’a birçok bölgede Türkiye’nin biyoçeşitliliği araştırılıyor
- Atatürk Üniversitesi ve Iğdır Üniversitesinden bilim insanlarının aralarında bulunduğu 5 kişilik ekip, hem bölgedeki böcek ve bitki türleriyle endemik…
Devamını Oku » - May- 2023 -3 MayısErzincan

Tercan petrolleri ne olacak?
Gabar Dağı’nda bulunan petrolün ardından Erzincan’ın Tercan ilçesi yakınlarında önceki yıllarda yapılan keşfin yeniden gündeme gelmesine sebep oldu
Devamını Oku »